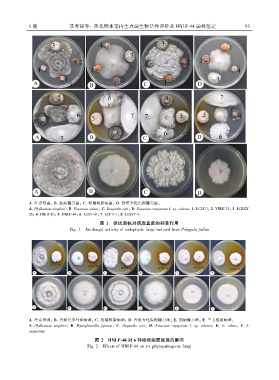

Page 97 - 《广西植物》2023年第1期
P. 97
1 期 苏秀丽等: 黄花倒水莲内生真菌生物活性评价及 HNLF ̄44 菌株鉴定 9 3
A. 叶点霉菌ꎻ B. 茄病镰刀菌ꎻ C. 柑橘树脂病菌ꎻ D. 香蕉专化尖孢镰刀菌ꎮ
A. Phyllosticta zingiberiꎻ B. Fusarium solaniꎻ C. Diaporthe citriꎻ D. Fusarium oxysporum f. sp. cubense. 1. LCLF ̄7ꎻ 2. YNLF ̄32ꎻ 3. LCRXY ̄
26ꎻ 4. HNLF ̄10ꎻ 5. HNLF ̄44ꎻ 6. LCSY ̄43ꎻ 7. LCPH ̄1ꎻ 8. LCSXY ̄9.
图 1 供试菌株对病原真菌的抑菌作用
Fig. 1 Antifungal activity of endophytic fungi isolated from Polygala fallax
A. 叶点霉菌ꎻ B. 香蕉具条叶斑病菌ꎻ C. 柑橘树脂病菌ꎻ D. 香蕉专化尖孢镰刀菌ꎻ E. 茄病镰刀菌ꎻ F. 三七根腐病菌ꎮ
A. Phyllosticta zingiberiꎻ B. Mycosphaerella fijiensisꎻ C. Diaporthe citriꎻ D. Fusarium oxysporum f. sp. cubenseꎻ E. F. solaniꎻ F. F.
oxysporum.
图 2 HNLF ̄44 对 6 种植物病原真菌的影响
Fig. 2 Effects of HNLF ̄44 on six phytopathogenic fungi